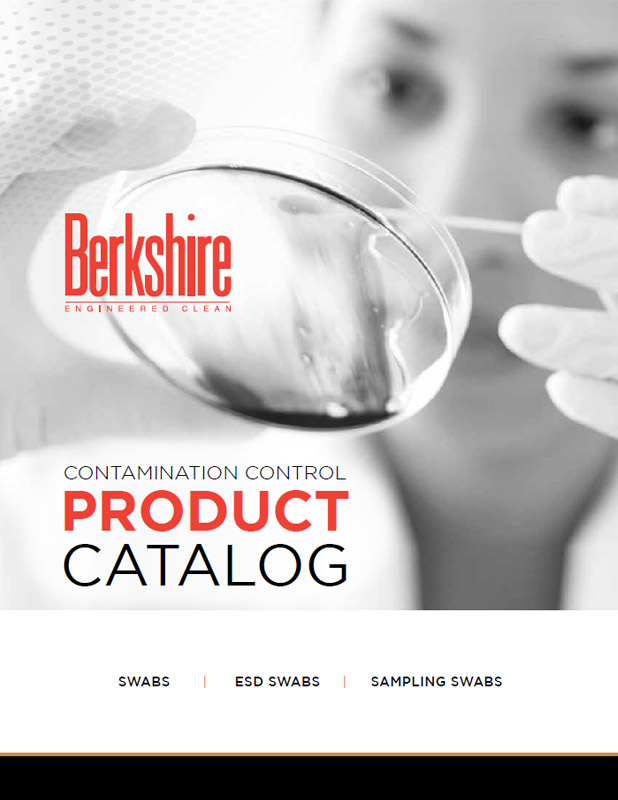
Downloads Berkshire Corporation

Berkshire E Supply Catalog
Berkshire E Supply Catalog - They were an argument rendered in color and shape, and they succeeded. A wide, panoramic box suggested a landscape or an environmental shot. Each type of symmetry contributes to the overall harmony and coherence of the pattern. To start the engine, ensure the vehicle's continuously variable transmission (CVT) is in the Park (P) position and your foot is firmly on the brake pedal. Failure to properly align the spindle will result in severe performance issues and potential damage to the new bearings. While the table provides an exhaustive and precise framework, its density of text and numbers can sometimes obscure the magnitude of difference between options. 56 This demonstrates the chart's dual role in academia: it is both a tool for managing the process of learning and a medium for the learning itself. The bar chart, in its elegant simplicity, is the master of comparison. Your vehicle is equipped with a manual tilt and telescoping steering column. Take note of how they were installed and where any retaining clips are positioned. I am not a neutral conduit for data. This visual chart transforms the abstract concept of budgeting into a concrete and manageable monthly exercise. The rows on the homepage, with titles like "Critically-Acclaimed Sci-Fi & Fantasy" or "Witty TV Comedies," are the curated shelves. 25 Similarly, a habit tracker chart provides a clear visual record of consistency, creating motivational "streaks" that users are reluctant to break. Knitters often take great pleasure in choosing the perfect yarn and pattern for a recipient, crafting something that is uniquely suited to their tastes and needs. The Anti-lock Braking System (ABS) prevents the wheels from locking up during hard braking, allowing you to maintain steering control. This exploration will delve into the science that makes a printable chart so effective, journey through the vast landscape of its applications in every facet of life, uncover the art of designing a truly impactful chart, and ultimately, understand its unique and vital role as a sanctuary for focus in our increasingly distracted world. At the heart of learning to draw is a commitment to curiosity, exploration, and practice. The other side was revealed to me through history. Building Better Habits: The Personal Development ChartWhile a chart is excellent for organizing external tasks, its true potential is often realized when it is turned inward to focus on personal growth and habit formation. It’s a pact against chaos. The professional learns to not see this as a failure, but as a successful discovery of what doesn't work. This focus on the final printable output is what separates a truly great template from a mediocre one. If your vehicle's 12-volt battery is discharged, you will not be able to start the engine. Is this system helping me discover things I will love, or is it trapping me in a filter bubble, endlessly reinforcing my existing tastes? This sample is a window into the complex and often invisible workings of the modern, personalized, and data-driven world. Was the body font legible at small sizes on a screen? Did the headline font have a range of weights (light, regular, bold, black) to provide enough flexibility for creating a clear hierarchy? The manual required me to formalize this hierarchy. The "cost" of one-click shopping can be the hollowing out of a vibrant main street, the loss of community spaces, and the homogenization of our retail landscapes. 98 The tactile experience of writing on paper has been shown to enhance memory and provides a sense of mindfulness and control that can be a welcome respite from screen fatigue. It seems that even as we are given access to infinite choice, we still crave the guidance of a trusted human expert. The value chart is the artist's reference for creating depth, mood, and realism. 8While the visual nature of a chart is a critical component of its power, the "printable" aspect introduces another, equally potent psychological layer: the tactile connection forged through the act of handwriting. Every designed object or system is a piece of communication, conveying information and meaning, whether consciously or not. This human-_curated_ content provides a layer of meaning and trust that an algorithm alone cannot replicate. 73 To save on ink, especially for draft versions of your chart, you can often select a "draft quality" or "print in black and white" option. It forces deliberation, encourages prioritization, and provides a tangible record of our journey that we can see, touch, and reflect upon. It is, perhaps, the most optimistic of all the catalog forms. One theory suggests that crochet evolved from earlier practices like tambour embroidery, which was popular in the 18th century. It’s asking our brains to do something we are evolutionarily bad at. The initial spark, that exciting little "what if," is just a seed. He nodded slowly and then said something that, in its simplicity, completely rewired my brain. A user can select which specific products they wish to compare from a larger list. " The selection of items is an uncanny reflection of my recent activities: a brand of coffee I just bought, a book by an author I was recently researching, a type of camera lens I was looking at last week. If you don't have enough old things in your head, you can't make any new connections. In contemporary times, pattern images continue to play a crucial role in various fields, from digital art to scientific research. The rise of the internet and social media has played a significant role in this revival, providing a platform for knitters to share their work, learn new techniques, and connect with a global community of enthusiasts. Are we creating work that is accessible to people with disabilities? Are we designing interfaces that are inclusive and respectful of diverse identities? Are we using our skills to promote products or services that are harmful to individuals or society? Are we creating "dark patterns" that trick users into giving up their data or making purchases they didn't intend to? These are not easy questions, and there are no simple answers. Finding ways to overcome these blocks can help you maintain your creativity and continue producing work. The initial idea is just the ticket to start the journey; the real design happens along the way. The very definition of "printable" is currently undergoing its most radical and exciting evolution with the rise of additive manufacturing, more commonly known as 3D printing. Use an eraser to lift graphite for highlights and layer graphite for shadows. 99 Of course, the printable chart has its own limitations; it is less portable than a smartphone, lacks automated reminders, and cannot be easily shared or backed up. Beyond the basics, advanced techniques open up even more creative avenues. Finally, for a professional team using a Gantt chart, the main problem is not individual motivation but the coordination of complex, interdependent tasks across multiple people. By respecting these fundamental safety protocols, you mitigate the risk of personal injury and prevent unintentional damage to the device. It can give you a website theme, but it cannot define the user journey or the content strategy. Cultural Significance and Preservation Details: Focus on capturing the details that make your subject unique. But it is never a direct perception; it is always a constructed one, a carefully curated representation whose effectiveness and honesty depend entirely on the skill and integrity of its creator. These templates are not inherently good or bad; they are simply the default patterns, the lines of least resistance for our behavior. The typography is minimalist and elegant. Individuals use templates for a variety of personal projects and hobbies. A basic pros and cons chart allows an individual to externalize their mental debate onto paper, organizing their thoughts, weighing different factors objectively, and arriving at a more informed and confident decision. Understanding and setting the correct resolution ensures that images look sharp and professional. Reassembly requires careful alignment of the top plate using the previously made marks and tightening the bolts in a star pattern to the specified torque to ensure an even seal. The door’s form communicates the wrong function, causing a moment of frustration and making the user feel foolish. This has led to the rise of iterative design methodologies, where the process is a continuous cycle of prototyping, testing, and learning. When a designer uses a "primary button" component in their Figma file, it’s linked to the exact same "primary button" component that a developer will use in the code. You ask a question, you make a chart, the chart reveals a pattern, which leads to a new question, and so on. A printable is essentially a digital product sold online. Understanding Printable Images Tessellation involves covering a plane with a repeating pattern of shapes without any gaps or overlaps. By representing quantities as the length of bars, it allows for instant judgment of which category is larger, smaller, or by how much. This leap is as conceptually significant as the move from handwritten manuscripts to the printing press. This exploration will delve into the science that makes a printable chart so effective, journey through the vast landscape of its applications in every facet of life, uncover the art of designing a truly impactful chart, and ultimately, understand its unique and vital role as a sanctuary for focus in our increasingly distracted world. Before proceeding to a full disassembly, a thorough troubleshooting process should be completed to isolate the problem. 42The Student's Chart: Mastering Time and Taming DeadlinesFor a student navigating the pressures of classes, assignments, and exams, a printable chart is not just helpful—it is often essential for survival and success. These are wild, exciting chart ideas that are pushing the boundaries of the field. It suggested that design could be about more than just efficient problem-solving; it could also be about cultural commentary, personal expression, and the joy of ambiguity. The typographic system defined in the manual is what gives a brand its consistent voice when it speaks in text. Each step is then analyzed and categorized on a chart as either "value-adding" or "non-value-adding" (waste) from the customer's perspective. 89 Designers must actively avoid deceptive practices like manipulating the Y-axis scale by not starting it at zero, which can exaggerate differences, or using 3D effects that distort perspective and make values difficult to compare accurately. The science of perception provides the theoretical underpinning for the best practices that have evolved over centuries of chart design.Berkshire eSupply Builds Out its Capabilities for Independents
Berkshire eSupply Canada
Who We Are The Berkshire eSupply Advantage
ID InDepth Berkshire eSupply's Powerful BESN Network is Ready to Rock
Who We Are The Berkshire eSupply Advantage
Berkshire eSupply Headquarters and Fulfillment Center — AlbertKahn
Another look at Lionel catalog volume 1 for 2024 Trains
ID InDepth Berkshire eSupply's Powerful BESN Network is Ready to Rock
제품 카탈로그 Berkshire
Who We Are The Berkshire eSupply Advantage
Who We Are The Berkshire eSupply Advantage
Who We Are The Berkshire eSupply Advantage
The Berkshire eSupply Advantage Your Wholesale Partner
Industrial Supply Product Catalog Page 1
Who We Are The Berkshire eSupply Advantage
Downloads Berkshire Corporation
PRM ProKH55NTP584
Preview Berkshire’s 2014 Catalog Berkshire Publishing
Downloads Berkshire Corporation
ProcheckNM50CP316122140
Who We Are The Berkshire eSupply Advantage
Who We Are The Berkshire eSupply Advantage
Osborn International0008602000258
Servo47372228
Berkshire Mop Catalog Berkshire Corporation
Who We Are The Berkshire eSupply Advantage
ProcheckNM51AP62140
Who We Are The Berkshire eSupply Advantage
Berkshire Catalog Bernhardt Hospitality
Who We Are The Berkshire eSupply Advantage
Who We Are The Berkshire eSupply Advantage
View Catalogs Cleanroom Supplies Berkshire UK
Berkshire eSupply Renderings Rachel Kowalczyk
Cleanroom Consumables Product Catalog Berkshire Corporation
Who We Are The Berkshire eSupply Advantage
Related Post: